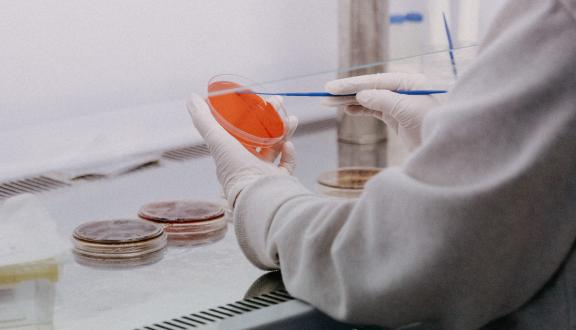

Guido Poli

Laureato in Medicina e Chirurgia a Ferrara (1982), inizia a fare ricerca su HIV/AIDS nel 1984 nel laboratorio d’Immunologia Umana diretta da Alberto Mantovani all’Istituto per le Ricerche Farmacologiche “Mario Negri” di Milano. Dal 1986 al 1993 è visiting scientist nel Laboratory of Immunoregualtion, diretto da Anthony S. Fauci all’NIAID, NIH. Bethesda, MD, USA. Dal 1994 dirige l’Unità d’Immunopatogenesi dell’AIDS all’IRCCS San Raffaele di Milano. Nel 2002 è assunto come professore associato di Patologia Generale presso l’Università Vita-Salute San Raffaele di Milano, promosso a professore ordinario nel 2016. È autore di oltre 250 pubblicazioni scientifiche, per la maggior parte dedicate alla patogenesi dell’infezione da HIV, per un IF complessivo >1.250 e un indice h di 55 (fonte: ISI).